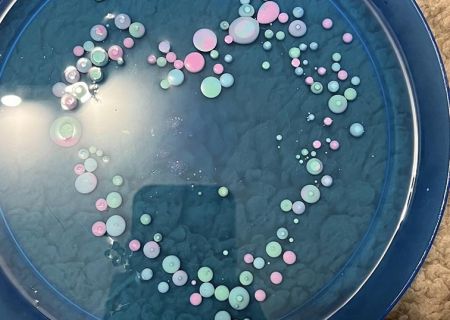
09
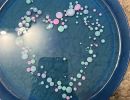
09

Zajęcia z integracji sensorycznej
Integracja Sensoryczna – wspieramy rozwój Twojego dziecka poprzez ruch i zabawę!
Zajęcia z integracji sensorycznej pomagają dzieciom lepiej radzić sobie z bodźcami zmysłowymi, rozwijać motorykę, koncentrację i umiejętności społeczne.
Kontrolowana zabawa pozwala dzieciom odkrywać swoje emocje i uczyć się, jak sobie z nimi radzić, a my kierujemy te działania tak, aby wspierać ich samoregulację i rozwój emocjonalny w przyjaznym, naturalnym dla dziecka świecie.
Podczas zajęć wykorzystujemy różnorodne pomoce i aktywności, które angażują wszystkie zmysły, pobudzają ciekawość i zachęcają do działania. Dzięki temu dzieci uczą się przez doświadczanie, co pozytywnie wpływa na ich pewność siebie i samodzielność. Każde spotkanie to nie tylko terapia, ale też radość z odkrywania swoich możliwości.
Dla kogo?
👶 Dla dzieci z trudnościami w przetwarzaniu bodźców sensorycznych
🧠 Dla dzieci z trudnościami z koncentracją i skupieniem uwagi
🌈 Dla dzieci nadwrażliwych lub mało wrażliwych na bodźce sensoryczne
🤸 Dla dzieci z problemami w koordynacji ruchowej
💫 Dla dzieci rozwijających się prawidłowo, które chcą wspierać swój rozwój, koncentrację i umiejętności społeczne
⏰ Czas trwania zajęć: 50 minut
📍 Miejsce: ul. Gałeczki 36, Chorzów
💰 Koszt:
• 120 zł – zajęcia indywidualne
• 160 zł – grupa 2 lub 3 dzieci
Umów wizytę i pozwól dziecku odkrywać swoje możliwość w przyjaznej dla niego formie!